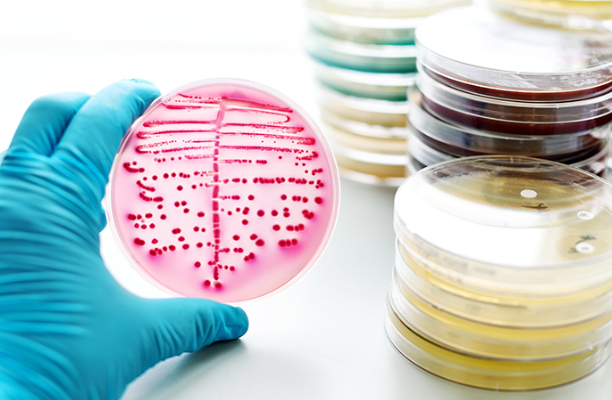
1754620085979163.png image.png

名字越長(zhǎng)專業(yè)越水?微生物與生化藥學(xué)同等學(xué)力申碩水不水?

在職考研招生網(wǎng)
2025-08-09 08:57:01
這個(gè)專業(yè)很實(shí)用,就業(yè)也好,根本不水。
名字越長(zhǎng)專業(yè)越水其實(shí)沒有什么根據(jù),可能有的人想說,有些專業(yè)明顯就是拼接出來的,很典型的就是這種格式“xxxx與xxx工程”,但這并不能說明什么問題。
很多人覺得名字長(zhǎng)的專業(yè)可能是拼接出來的,就比如常見的“xxxx與xxx工程”這種格式。
但這其實(shí)沒啥依據(jù)。
就拿信息管理與信息系統(tǒng)來說,名字又長(zhǎng)又專業(yè),聽著像是計(jì)算機(jī)與管理的完美結(jié)合,可實(shí)際上這個(gè)專業(yè)的課程確實(shí)包括了計(jì)算機(jī)和管理多方面的知識(shí),是培養(yǎng)能在信息系統(tǒng)分析、設(shè)計(jì)、實(shí)施等方面有能力的人才,你能說它水嗎?所以啊,不能光看名字長(zhǎng)短來判斷一個(gè)專業(yè)好不好。
微生物與生化藥學(xué)專業(yè)是啥
微生物與生化藥學(xué),是用生物合成的方法開發(fā)藥物。
它主要研究微生物藥物、生物技術(shù)藥物和生化藥物的新藥發(fā)現(xiàn)、研究開發(fā)、生產(chǎn)技術(shù)、質(zhì)量控制及臨床應(yīng)用的理論和技術(shù)。
打個(gè)比方,像是我們?nèi)粘3缘囊恍┛股兀芏嗑褪峭ㄟ^微生物發(fā)酵等技術(shù)生產(chǎn)出來的,這背后就離不開微生物與生化藥學(xué)專業(yè)的研究。
這個(gè)專業(yè)的同學(xué),三年基本都和細(xì)胞、菌株打交道,要掌握寬廣的藥學(xué)和生物學(xué)基礎(chǔ)知識(shí)、理論和技能,還要系統(tǒng)地學(xué)習(xí)有機(jī)化學(xué)的專門知識(shí)。
這個(gè)專業(yè)的就業(yè)前景那是相當(dāng)不錯(cuò)。
隨著生物技術(shù)的發(fā)展,它的應(yīng)用越來越廣泛,市場(chǎng)需求也在不斷增加。
從就業(yè)方向來看,畢業(yè)生可以在多個(gè)行業(yè)找到工作。

行業(yè) | 崗位 |
醫(yī)藥行業(yè) | 藥品研發(fā)、質(zhì)量檢測(cè)、銷售與市場(chǎng)等 |
生物技術(shù)行業(yè) | 科研人員、生物制品研發(fā)等 |
食品行業(yè) | 食品質(zhì)量檢測(cè)等 |
環(huán)保行業(yè) | 環(huán)境微生物檢測(cè)等 |
在醫(yī)藥行業(yè),能在制藥企業(yè)從事新藥研發(fā)、臨床試驗(yàn)等工作。
現(xiàn)在大家對(duì)健康越來越重視,新藥研發(fā)一直是熱門,企業(yè)也愿意花高薪聘請(qǐng)專業(yè)人才。
在質(zhì)量檢測(cè)方面,不管是藥品、食品還是環(huán)保領(lǐng)域,都需要專業(yè)人員把控質(zhì)量。
像食品行業(yè),要檢測(cè)食品里有沒有微生物超標(biāo)啥的,這就需要微生物與生化藥學(xué)專業(yè)知識(shí)。
剛畢業(yè)的起薪也還不錯(cuò)。
根據(jù)一些數(shù)據(jù)統(tǒng)計(jì)(當(dāng)然這些數(shù)據(jù)會(huì)因?yàn)榈貐^(qū)、企業(yè)規(guī)模等因素有差異),一般來說,從事微生物與生化藥學(xué)相關(guān)工作的畢業(yè)生,月薪在8k-15k左右的比較多。
比如說在一些一線城市,做微生物研發(fā)工程師,平均月薪能達(dá)到10.9k左右;要是做化妝品研發(fā)相關(guān)工作,像化妝品研發(fā)工程師平均月薪能到15.9k。
在二三線城市,起薪可能會(huì)低一些,但也能有個(gè)6k-8k左右,干時(shí)間長(zhǎng)了工資會(huì)更高。
-
統(tǒng)計(jì)學(xué)在職研究生有用嗎? 提高專業(yè)水平有用嗎?
2023-12-28 07:48:22

-
湖南大學(xué)同等學(xué)力申碩專業(yè)有哪些?不同專業(yè)學(xué)費(fèi)一樣嗎?
2023-12-28 10:39:59

-
同等學(xué)力申碩專業(yè)有哪些?招生專業(yè)匯總
2023-12-29 10:05:56

-
在職研究生入學(xué)用不用參加考試? 同等學(xué)力申碩 專業(yè)碩士
2023-12-12 14:08:54

-
在職研究生平時(shí)怎么上課?老師的水平怎么樣?
2024-01-09 08:22:15

-
同等學(xué)力申碩的專業(yè)有哪些?有不考英語(yǔ)的嗎?
2023-12-29 10:15:56

-
化學(xué)在職研究生報(bào)考條件是什么?同等學(xué)力和專業(yè)碩士
2023-12-28 08:52:44

-
在職研究生報(bào)考名校難度大嗎? 越知名院校的報(bào)考難度越大嗎?
2023-12-20 10:53:14

-
在職研究生網(wǎng)上報(bào)名什么時(shí)候? 同等學(xué)力申碩 專業(yè)碩士
2023-12-20 10:46:07

-
在職研究生的報(bào)名門檻高嗎? 同等學(xué)力申碩和專業(yè)碩士
2023-12-18 10:31:43

-

非全日制研究生大學(xué)有哪些? (附2024招生一覽表)

-
1
教育學(xué)非全日制研究生招生院校有哪些? (推薦五所學(xué)校)

-
2
中山大學(xué)在職研究生學(xué)費(fèi)一覽表

-
3
工程類非全日制研究生招生院校有哪些?(附九所學(xué)校專業(yè)一覽表)

-
4
非全日制研究生上課時(shí)間怎么安排?寒暑假有上課安排嗎?
-
5
杭州非全日制研究生招生院校有哪些?(附學(xué)校專業(yè)推薦)
-
6
安徽在職研究生學(xué)費(fèi)一覽表 (附學(xué)校推薦)
-
7
深圳在職研究生有哪些學(xué)校?多個(gè)院校介紹
-
8
2025年全日制研究生學(xué)費(fèi)一覽表,5萬(wàn)到30萬(wàn)都有!
-
9
2023年北京在職研究生落戶政策是怎么樣的?
-

我想考博,請(qǐng)問考博一定要聯(lián)系導(dǎo)師嗎?求解

-
1
過來人能說一下考研復(fù)試分?jǐn)?shù)怎么算的嗎?在線等

-
2
各位學(xué)長(zhǎng),山東師范大學(xué)研究生院好考嗎?有什么答題技巧分享一下嗎?

-
3
請(qǐng)問研究生考試幾天?主要考什么?

-
4
想知道與考研相比考博真的容易嗎?
-
5
雙證在職博士能到高校當(dāng)老師嗎?
-
6
在職研究生含金量高嗎?好找工作嗎?
-
7
想知道同等學(xué)力國(guó)考考什么?通過率怎么樣?
-
8
請(qǐng)問學(xué)姐們,遼寧師范大學(xué)研究生院學(xué)費(fèi)是多少?每個(gè)專業(yè)都一樣嗎?
-
9
會(huì)計(jì)研究生幾年學(xué)制?想知道哪個(gè)學(xué)校好考?
-
2026非全研網(wǎng)上確認(rèn)別踩雷:材料、時(shí)間、流程3大關(guān)鍵提醒
非全日制研究生 2025-11-03
-
備考2026非全研:初試審查“考幾天”是關(guān)鍵,別因時(shí)間誤考
非全日制研究生 2025-11-03
-
中國(guó)民航大學(xué)非全日制研究生報(bào)名截止27號(hào),目前不能再報(bào)了!
非全日制研究生 2025-11-02
-
讀山大非全碩士要幾年?2026招生簡(jiǎn)章學(xué)制細(xì)則+延期規(guī)定
非全日制研究生 2025-11-02
-
廣東醫(yī)科大學(xué)2026非全公管學(xué)費(fèi)定了:一年24000,值得報(bào)嗎?
非全日制研究生 2025-11-01
-
同等學(xué)力申碩考公務(wù)員有限制嗎?
同等學(xué)力 2024-07-14

-
2025國(guó)外碩士能在國(guó)內(nèi)考博嗎?
在職博士 2024-07-14

-
2024心理學(xué)研究生要考哪些科目?
全日制研究生 2024-07-14

-
2024考研沒考上怎么辦該放棄嗎?
全日制研究生 2024-07-14

-
2025報(bào)考非全日制研究生難度大嗎?
非全日制研究生 2024-07-14

-
2025考博準(zhǔn)備多久比較合適?
在職博士 2024-07-13

-
2025壓力大不想考研了怎么辦能平復(fù)這種心理?
全日制研究生 2024-07-13

-
2025考研單科不過線怎么辦?
全日制研究生 2024-07-13

-
2025免聯(lián)考mba是啥?
非全日制研究生 2024-07-13

-
2025零基礎(chǔ)考研數(shù)學(xué)怎么學(xué)?
全日制研究生 2024-07-13
